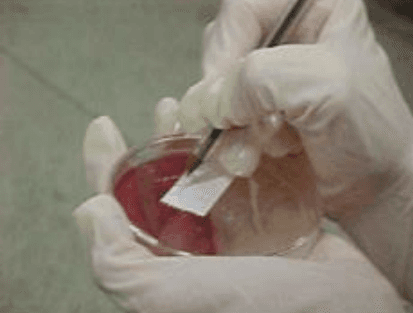

OBJETIVO
1.1 Organizar as rotinas de monitorias do programa de limpeza e desinfecção realizado
no incubatório.
2. CAMPO DE APLICAÇÃO
2.1 Este procedimento aplica-se ás áreas de qualidade e incubatório da empresa.
3. DEFINIÇÕES
3.1 Não aplicável.
4. DESCRIÇÃO DA ATIVIDADE
4.1 Materiais necessários:
Placas de petri (Sabbound e macconkey)
Toca descartável
Luva descartável
Caixa de isopor ou outro material isolante térmico
Embalagem para coleta de material
Caneta
Gelo
Álcool
Bombinha
Caixa plástica para plaqueamento
Relógio
Respirador fácil
4.2 Responsabilidade
a) Funcionário: exposição das placas.
b) Gerente do Incubatório: monitoramento.
c) Veterinários: verificação.
4.3 Metodologia e Frequência: realizado semanalmente, após a limpeza e
desinfecção de todas as áreas do incubatório. Toda a atividade deve ser feita com
luvas desinfetadas antes de posicionar cada placa.
a) Exposição das Placas
• Exponha as placas de petri, sendo 1 placa para os dutos de cada ar condicionado ou HVAC; 1 placa para 100 m3 (5 m x 5 m x 4 m).
Abra a embalagem plástica contendo as placas.
Retire as placas colocando na caixa plástica de pintos.

Umedeça a mão (com luva látex) com álcool antes de tocar cada placa de coleta.

Identifique com fita crepe o número do ponto de coleta.
Coloque as placas ainda fechadas nos locais determinados.

Afaste o corpo/membros e abra a placa de coleta suavemente.
Deixe a tampa virada para cima ao lado da placa e aguarde 15 minutos para recolher.

Mantenha a embalagem plástica com as placas na caixa de isopor.
Coloque as placas na caixa de isopor viradas com as tampas para
baixo.Lacre a caixa com fita adesiva e informe o superior.

identificar com etiqueta de “FRÁGIL E DEIXAR PARA CIMA”
Enviar refrigerado para o laboratório com gelo gel (Gelox)
Não deixar espaços livre dentro da caixa de isopor (preencher com gelo ou papel amassado para preencher os espaços vazios e na o corres o risco de tombar.
Dados para envio das amostras
LAUDO LABORATÓRIO AVÍCOLA UBERLÂNDIA LTDA CNPJ: 23.259.427/0001-04 – I.E: 7023871770001 – RODOVIA BR 365, KM 615 – S/N – ALVORADA – 38407-180 – UBERLÂNDIA/MG

